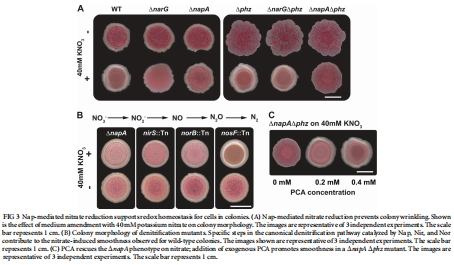

熱線:021-66110810,66110819
手機:13564362870

熱線:021-66110810,66110819
手機:13564362870
Bacterial Community Morphogenesis Is Intimately Linked to the Intracellular Redox State
細菌群落形態發生與細胞內氧化還原狀態密切相關
來源:Journal of Bacteriology p. 1371–1380
1. 摘要核心內容
該論文摘要指出,許多微生物物種會形成包含復雜褶皺和同心環的多細胞結構,但其構建規則尚不明確。機會性病原體銅綠假單胞菌會產生吩嗪,這類小分子可作為氧氣和硝酸鹽的替代電子受體,氧化細胞內氧化還原狀態,并影響生物膜形態發生。本研究表明,菌落生物膜中細胞占據的深度與電子受體的可利用性密切相關。環境提供、內源性產生和利用電子受體方面的擾動,會以符合氧化還原調控的方式影響菌落發育。細胞內NADH水平在菌落褶皺誘導前達到峰值。這些結果表明,氧化還原失衡是驅動銅綠假單胞菌生物膜形態發生的主要因素,而褶皺本身是一種適應,旨在最大化氧氣可及性,從而支持代謝穩態。這種氧化還原驅動的形態變化讓人聯想到后生動物中發生的發育過程。
2. 研究目的
本研究旨在直接驗證以下假設:吩嗪的產生和菌落褶皺是幫助細胞應對電子受體限制的適應策略。具體目標是探究細胞內氧化還原狀態(而非僅僅是吩嗪本身)是否與菌落形態發育相關,并測試內源性電子穿梭體(如吩嗪)是否能增加生物膜細胞的可居住區域。
3. 研究思路
研究采用遺傳學、顯微成像、化學測量相結合的思路,系統性地關聯了氧化還原代謝與形態發育:
構建遺傳背景清晰的菌株:使用野生型、吩嗪缺失突變株(△phz)、硝酸鹽還原酶突變株(△napA, △narG)以及多糖合成缺陷株(△pel)等,以操控電子受體利用和內源性氧化劑產生。
在不同氧化條件下培養:在常氧(21%)、高氧(40%)、低氧(15%)及缺氧條件下培養菌落生物膜,改變外部電子受體(氧氣、硝酸鹽)的可利用性。
多維度表征與關聯:
使用Unisense氧微電極測量生物膜內部的氧氣深度分布。
通過熒光顯微技術(使用組成型表達YFP的菌株)觀察并量化菌落切片中的細胞分布深度。
測量菌落發育過程中的NADH/NAD?比率,以監測細胞內氧化還原狀態。
量化菌落的形態特征(如褶皺厚度、表面覆蓋度)。
機制推斷:將上述測量結果進行關聯,論證氧化還原狀態、電子受體可用性、細胞分布深度和菌落形態之間的因果關系。
4. 測量的數據、研究意義及來源
氧氣深度分布:使用Clark氧電極測量發現,在菌落基部區域,氧氣在表面以下60微米處即檢測不到(圖1B)。但在正在形成的褶皺中,氧氣衰減更慢,且較薄的褶皺比較厚的褶皺缺氧程度更輕(圖1D)。意義:直接證實了生物膜內部存在強烈的氧氣梯度,且褶皺結構能更有效地將氧氣輸送至深層,這為理解其功能提供了物理化學基礎。數據來自圖1B和D。

細胞分布深度:對組成型表達YFP的菌落進行切片和熒光成像分析。數據顯示,在常氧下,△phz突變株的細胞僅分布在表面以下60微米的富氧區,而野生型菌株的細胞可分布至100微米深度,即進入了40微米厚的缺氧區(圖2G)。改變環境氧濃度(15%, 40%)時,兩種菌株的細胞層厚度隨之變化,但野生型始終厚于△phz突變株。意義:首次直接證明吩嗪的存在擴大了生物膜中的可居住區域,使細胞能在缺氧層存活,支持了吩嗪作為“呼吸色素”的古老假說。數據來自圖2A-G及補充圖S1。

菌落形態對外部氧濃度的響應:隨著環境氧濃度增加(從15%到40%),菌落的表面覆蓋度減小,形成的褶皺減少,但褶皺的厚度增加(圖2H和I)。意義:表明菌落形態可塑性是對氧化條件的主動適應。氧濃度越高,對增加表面積(形成多而薄的褶皺)的需求越低,因此傾向于形成更少、更厚的結構。數據來自圖2H和I。
硝酸鹽對形態的調控:在培養基中添加硝酸鹽可使△phz突變株的菌落變平滑。遺傳學實驗表明,這一平滑表型依賴于周質硝酸鹽還原酶NapA,而不依賴于產能的細胞質硝酸鹽還原酶NarG,并且需要下游的硝化作用(Nir, Nor)(圖3A, B)。添加吩嗪PCA也能使△napA △phz雙突變株在硝酸鹽存在下變平滑(圖3C)。意義:證明除了吩嗪,利用硝酸鹽(通過Nap系統)平衡細胞內氧化還原態同樣能抑制褶皺形成,進一步將形態與氧化還原穩態而非特定分子直接關聯。數據來自圖3A-C及補充圖S2。
NADH/NAD?比率動態:測量菌落發育過程中的NADH/NAD?比率。發現△phz突變株的NADH/NAD?比率在褶皺開始形成時達到峰值,而野生型菌株的比率在整個過程中保持相對穩定(圖4B)。在無法形成褶皺的△phz △pel雙突變株中,該比率峰值持續存在(圖5B)。意義:提供了細胞內還原壓力(高NADH/NAD?比率)是觸發褶皺形態轉換的直接信號的關鍵證據。褶皺形成后,該比率下降,表明其功能是恢復氧化還原平衡。數據來自圖4B和圖5B。


5. 研究結論
銅綠假單胞菌生物膜內部的細胞分布深度與電子受體(氧氣)的可利用性嚴格一致。吩嗪作為電子穿梭體,能擴展細胞在缺氧層的存活空間。
菌落褶皺的形態發生是對細胞內氧化還原失衡的主動適應。當電子受體受限導致NADH/NAD?比率升高(還原壓力增大)時,菌落通過增加表面積(形成褶皺)來最大化與氧氣的接觸,從而恢復氧化還原穩態。
多種氧化還原平衡機制(內源性吩嗪、外源性硝酸鹽通過Nap系統還原)都能抑制褶皺形成,表明是氧化還原狀態本身,而非特定分子,調控著形態。
這種氧化還原驅動的多細胞形態發生,在策略上與后生動物(如血管生成應對缺氧)具有保守性,表明其為一種跨界的生物學適應原理。
6. 詳細解讀:使用丹麥Unisense電極測量數據的研究意義
本研究中,所有關于生物膜內部氧氣微環境的數據均通過丹麥Unisense公司的微型Clark型氧傳感器(尖端直徑10 μm)測量獲得。該數據是本研究的核心實驗支柱,具有以下不可替代的關鍵意義:
提供了“形態-功能”假說的直接空間物化證據:本研究的核心假設是:菌落褶皺是一種增加氧氣可及性的適應性狀。Unisense氧電極以微米級空間分辨率描繪的氧氣剖面圖(圖1B, D),為這一假設提供了最直接的證明。數據顯示,在平坦的菌落基部,氧氣在60微米處耗盡,這定義了不產吩嗪細胞的理論生存極限。而正是在氧氣衰減更慢的褶皺區域,細胞分布更深。這份高分辨率的化學成像將“褶皺”這個形態學特征,與“改善內部氧化條件”這個物理學功能,在空間上直接、定量地關聯起來,使假說得以證實。
量化了氧化還原微環境,為數學模型和機制推斷奠定了基礎:電極測量不僅提供了定性的趨勢,更重要的是提供了定量的梯度數據。氧氣滲透深度(~60 μm)和褶皺與基部衰減曲線的差異,是評估生物膜內物質傳輸與消耗動態的關鍵參數。這些數據為后續可能進行的擴散-反應數學模型構建提供了邊界條件和驗證基準。同時,測量表明即使在常氧大氣下,生物膜內部也極快形成缺氧區,這凸顯了電子受體限制是生物膜細胞的固有挑戰,從而解釋了為何需要吩嗪、褶皺等復雜的適應策略。
架起了連通“宏觀形態”與“微觀細胞生理”的橋梁:研究通過電極數據明確了“缺氧區”的物理存在和范圍,再通過熒光顯微技術觀察到細胞確實能(在吩嗪幫助下)定居于此缺氧區。這兩組數據的結合,完美詮釋了吩嗪的生理功能:它將細胞的可居住空間從電極定義的“富氧區”拓展到了“缺氧區”。沒有電極對化學環境的精確界定,細胞分布的變化就失去了其明確的生理學意義(是偏好缺氧還是被迫滯留?)。電極數據使得“擴展可居住區”這一功能得以被清晰定義和證實。
支撐了“氧化還原狀態是核心調控信號”的最終結論:研究最終結論是形態由細胞內氧化還原狀態(NADH/NAD?比率)驅動,而非氧氣濃度本身。Unisense電極數據在此起到了關鍵的“辨因”作用。它證實無論野生型還是△phz菌株,其基部的氧氣梯度是相似的(圖1B),但它們的形態和細胞分布卻不同。這排除了“局部氧氣濃度絕對值”作為直接形態誘導信號的可能性,從而將研究者的視角引向細胞對相同氧化壓力產生的不同生理響應(如能否通過吩嗪維持氧化還原平衡),最終聚焦于NADH/NAD?比率這一更本質的細胞狀態指標。
綜上所述,在這項經典的生物膜研究中,丹麥Unisense氧微電極系統是將“黑箱”般的生物膜結構打開,并對其內部化學驅動力量進行實證研究的鑰匙。其提供的原位、實時的氧氣微剖面數據,不僅是描述現象的工具,更是辨析機制、連接不同尺度(形態-化學-生理)觀測的核心證據。它使得關于生物膜適應性的研究,從相關的形態學描述,邁向了因果關聯的機理闡釋,極大地深化了我們對多細胞微生物群落生存策略的理解。